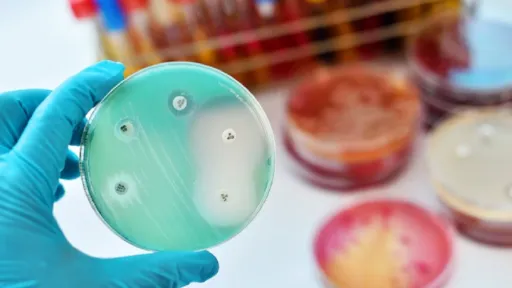

Boala care va lua 40 de miliaone de vieți până în 2050. OMS o consideră una dintre cele mai importante amenințări la nivel mondial pentru sănătatea publică și dezvoltare, care a contribuit la 1,27 milioane de decese la nivel global în 2019, scrie doctorulzilei.ro.
Numărul deceselor cauzate de „super-bacteriile” rezistente la medicamente ar urma să crească cu circa 50% , comparativ cu 2019, a arătat un studiu. recent.
Rezistența antimicrobiană apare atunci când infecțiile devin dificil de tratat, deoarece agentul patogen care provoacă infecția se adaptează la antibiotice din cauza utilizării excesive și a utilizării lor greșite.
Boala care ar urma să ucidă în jur de 40 de milioane de oameni până în 2050
În cel mai recent studiu publicat în The Lanchet, cercetătorii de la Global Research on Antimicrobial Resistance Project, Institute for Health Metrics and Evaluation și alte instituții au prezentat prima evaluare cuprinzătoare a poverii globale a rezistenței antimicrobiene din 1990 până în 2021 și au proiectat-o până în 2050.
„Medicamentele antimicrobiene sunt una dintre pietrele de temelie ale asistenței medicale moderne, iar creșterea rezistenței la acestea este un motiv major de îngrijorare. Aceste constatări evidențiază faptul că rezistența la antimicrobiene este o amenințare semnificativă pentru sănătatea globală de decenii și că această amenințare este în creștere.
Înțelegerea modului în care tendințele în decesele antimicrobiene s-au schimbat de-a lungul timpului și modul în care este probabil să se schimbe în viitor, este vital pentru a lua decizii informate pentru a ajuta la salvarea de vieți”, a declarat autorul studiului, dr. Mohsen Naghavi, într-un comunicat de presă.
În cadrul studiului, cercetătorii au estimat decesele și bolile atribuite rezistenței antimicrobiene pentru 22 de agenți patogeni, 84 de combinații de agenți patogeni-medicamente și 11 infecții în 204 țări și teritorii, între 1990 și 2021.
Ei au remarcat apoi o tendință interesantă:
- o scădere a deceselor cauzate de rezistența la antimicrobiene cu aproximativ 50% în rândul copiilor mai mici de 15 ani;
- o creștere a acestora cu peste 80% în rândul adulților de 50 de ani și peste.
Grupa de vârstă cea mai impactată
Potrivit rezultatelor studiului, Asia de Sud, America Latină și Caraibe sunt „super-regiuni cu cea mai mare rată a mortalității de rezistență la antimicrobiene pentru toate vârstele în 2050”. După analizarea diferitelor grupe de vârstă, cel mai mare impact a fost observat în rândul celor de 70 de ani și peste.
Cu toate acestea, cu un acces îmbunătățit la îngrijiri medicale și antibiotice, un total de 92 de milioane de vieți ar putea fi salvate între 2025 și 2050, au observat cercetătorii.